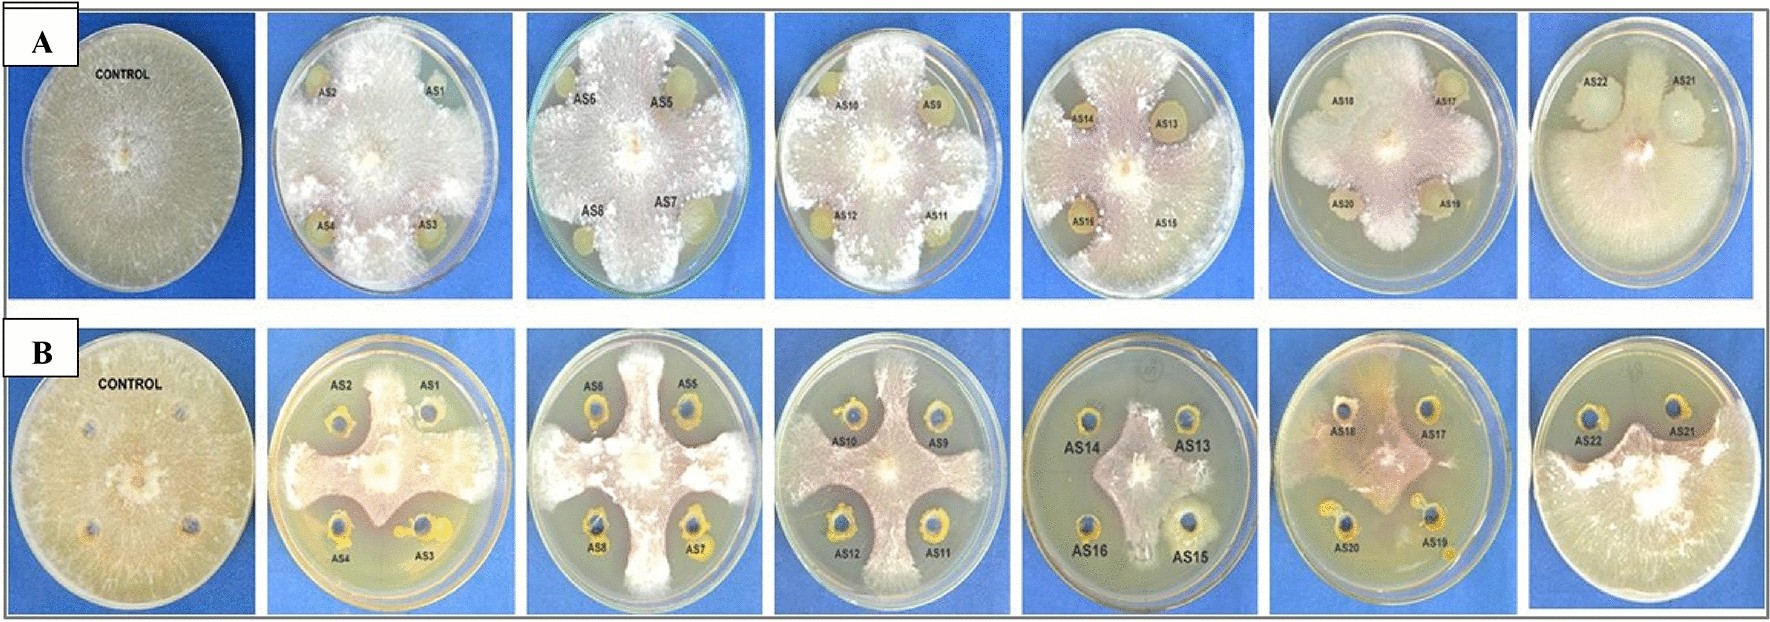
Figure 1

Figure 1
In vitro antagonistic assay between rhizobacteria strains (AS1-AS21) and Rhizoctonia solani f. sp. sasakii by dual-culture assays on PDA medium 7 days after incubation. (A) Whole cell mediated dual assay; (B) cell free filtrate mediated dual assay.